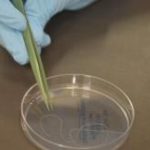

Felipão será o técnico gremista para a sequência do mandato de Fábio Koff. Depois de informações de que o técnico não gostaria de assumir um clube novamente no segundo semestre de 2014, Koff viajou até São Paulo ara convencê-lo. O ex-treinador da Seleção Brasileira chegará nesta quarta-feira a Porto Alegre e será apresentado oficialmente.rnEm São Paulo, ao lado do advogado do departamento de futebol Gabriel Vieira, o presidente acertou os termos para um novo acordo. Com a efetivação de André Jardine para auxiliar-técnico permanente do clube, Felipão deve indicar apenas Darlan Schneider para ser incorporado ao clube, mas como um assistente. Fábio Mahseredjian seguirá no comando da preparação física do clube. Murtosa, companheiro de longa data, não estaria nos planos para o trabalho no Grêmio.rnrnUm patrocinador ajudará o Grêmio a bancar o salário de Felipão.
Fonte: Zero Hora – Foto: Gaspar Nóbrega